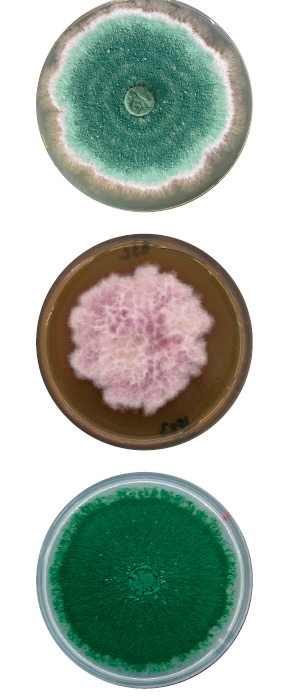
Processo produttivo

Processo produttivo
Il piano produttivo su scala industriale di XEDA ITALIA prevede sia lo SVILUPPO che lo SCALEUP dei processi di fermentazione dei microrganismi antagonisti di agenti fitopatogeni, partendo dal laboratorio e finendo nel bioreattore. I ceppi batterici e fungini utilizzati nelle nostre formulazioni sono regolarmente depositati presso Collezioni di Microrganismi riconosciute a livello internazionale, garantendone la conservazione e la purezza. I processi di produzione sono accuratamente STANDARIZZATI in modo da GARANTIRE formulati con caratteristiche ed attività COSTANTI.
Processo di produzione standardizzato:
- Preparazione dell’inoculo nel laboratorio microbiologico
- Produzione industriale nel bioreattore
- Raccolta della biomassa
- Formulazione e stabilizzazione
- Confezionamento
Produzione industriale in bioreattore:
Dopo aver superato tutti i test di laboratorio, le colture liquide sono utilizzate per l’inoculazione del bioreattore da 1500 litri, dove avviene la crescita del microrganismo e l’ottenimento della biomassa relativa In queste fasi, si opera ovviamente in condizioni di assoluta sterilità.
Durante tutte le fasi del processo produttivo è previsto un rigoroso piano di controllo qualitativo, che permette di ottenere formulati commerciali con caratteristiche estremamente costanti ed elevata qualità, vengono effettuati test biochimici, osservazioni microscopiche e analisi morfologiche.